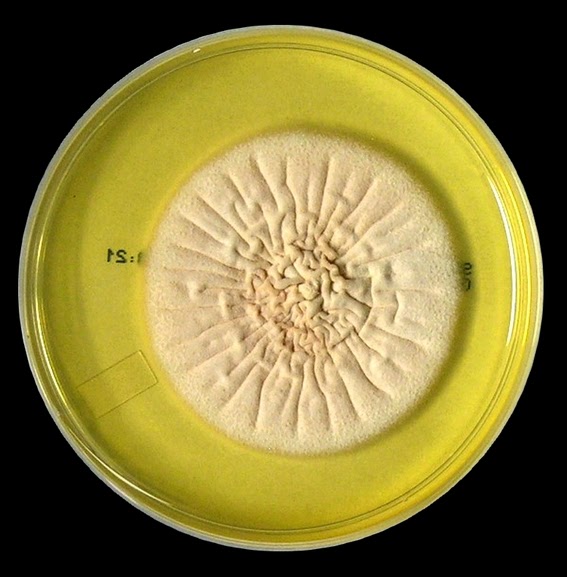
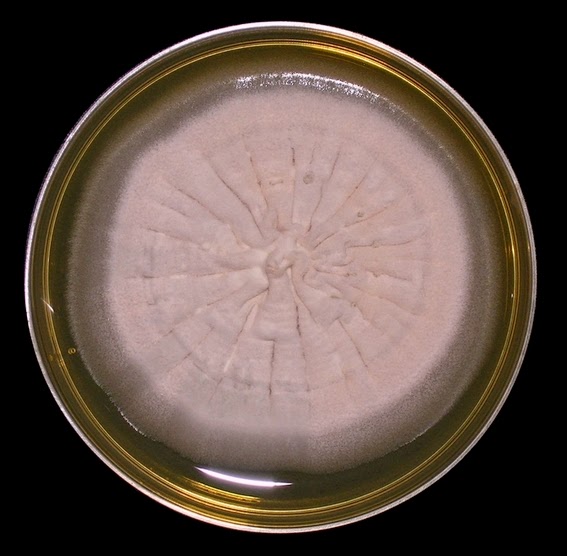

Acremonium species -Hypocreaceae Family (obsolete name Cephalosporium spp.)
Ecology:
Acremoniumspecies are yet another cosmopolitan fungus (ie. found just about everywhere) which can be isolated from soils as well as decaying plant material. There are about one hundred recognized species of Acremonium.
Pathogenicity:
Acremoniumspecies is associated with ‘white grain mycetoma’[i], an infection most commonly of the foot. Acremonium has also been implicated in meningitis, endocarditis, endophthalmitis and corneal ulcers. Onychomycosis or ‘tinea unguium’ (fungal infections of the nail) may also be caused by localized infection with Acremonium. Disseminated infections are rare and may result from traumatic injury and may be more likely in immunocompromised hosts.
Macroscopic Morphology:
Acremonium exhibits moderately rapid growth, rather flat colonies that may be slightly raised in the center. The colony has been described as glabrous to membrane-like initially, becoming powdery, cottony or even felt-like as it matures. The colony may be white to cream in appearance or even yellowish to coral or pinkish in colour. The reverse is pale, yellowish to pinkish in colour.
Acremonium species -Sabouraud Dextrose Agar (SAB) incubated at 30˚C for 18 days. (Nikon)
Acremonium species -Sabouraud Dextrose Agar (SAB) incubated at 30˚C for ~21 days. (Nikon)
Note -On the Challenges of Plate Photography:
This is the same species as above with a few more days of incubation. The reason I posted both these photos is to show the difficulty I have in expressing the true colour (and often texture) of the fungus even when grown on the same media and under identical conditions. The first photo was taken with the plate placed against a white background and the second against a black background.
The other challenge is lighting. I take these photos for my own entertainment and education - for "fun" as the title of the blog states. The acute care lab I work out of is interested only in a quick and accurate identification of fungi in clinical specimens. Documentation by photography is not a concern and we have no professional set up for taking photographs. I have rigged up my own apparatus for use as a camera stand for use within a biological safety cabinet (BSC) (see the post entitled 'Toys'). Photography of macroscopic plates is confined to the BSC as the lab could quickly become contaminated with spores if fungal plates were to be examined outside of the BSC. Many fungi produce vast quantity of spores which can become airborne with only the slightest breeze.
I have little control over the lighting. I often take a large number of photos using both white and black backgrounds. I simply use a sheet of white paper which I have run through a photocopier without a "target". In other words, I leave the cover of the photocopier open and "copy the air" which results in a sheet of paper covered with back toner on one side but white on the back. I can flip this paper over to the black or white side as I wish and as the background paper may be contaminated with spores, I can discard it safely when finished.
I use the fluorescent tube lighting of the BSC itself, I have an incandescent source of lighting I can bring into the cabinet, and I can use the flash unit on the camera itself in order to manipulate lighting. Light coloured fungi often show more detail when on a dark background and dematiacious fungi (darkly pigmented) stand out better on white backgrounds - but not always! I try to avoid cast shadows. I also find that the flash often produces such glare and reflection off of the petrie dish and agar surface that it obscures the true nature of the organism. By taking a large number of photos on various backgrounds and with various combinations of the lighting I have available, I can usually find a photograph that reflects the true characteristics of the fungus I am attempting to document.
Microscopic Morphology:
Acremoniumproduces septate hyphae from which erect, unbranched and tapering phialides extend. Most phialides (but not necessarily all) have a basal septum which delimits them from the hyphae proper. Conidia are oblong (2–3 X 4–8 µm) are usually one-celled, however bicellular conidia may occur. The conidia are produced and accumulate as balls (rarely as chains) at the apices of the phialides but they are fragile and easily disrupted.
Phialide: A specialized conidiogenous cell (conidiophore) that produces conidia in basipetal succession without increasing in length. (Mycology Online)
Acremoniumspecies - above is a little piece of agar which adhered to the slide culture microscope cover slip when removed from the agar block (See Post on Slide Cultures). From this little flake of agar you can see phialide extending outwards with little "balls" of conidia attached at their apices. (LPCB, DMD-108, 250X)
Acremoniumspecies - a collection of hypha run through the center of the photo from which you can see the phialide bearing conidia at their apices. This is like "micro-botany" with the fungi as tiny plants, the 'seeds' (conicia) at the tips of the stems. (LPCB, DMD-108, 400X)
Acremoniumspecies - As above but at a slightly higher magnification.
(LPCB, DMD-108, 400+10X)
Acremoniumspecies - the individual conidia can now be seen, gathered at the tapering tips of the phialides. (LPCB, DMD-108, 1000X)
Acremoniumspecies - not the greatest shot but try to picture the three 'balls' of conidia siting at the top of the phialides which are extending upwards, towards you, the viewer. The phialides are blurred (out of focus) as they are out of the focal plane of the camera, lying beneath the balls of conidia, where they attach to the hyphae. (LPCB, DMD-108, 1000X)
Acremoniumspecies - The same as above but viewed more from the side. The originating hyphae and tapering phialides are slightly out of the focal plane of the camera. The conidia that were produced at the apex of the phialide remains undisturbed as a ball around the top.
(LPCB, DMD-108, 1000_10X)
Acremoniumspecies - The previous photos show the phialides and conidia almost in three-dimensions. In the photos that follow, they are lying fairly flat, making it easier to see the features.
(LPCB, Nikon, 400X)
Acremoniumspecies - in the center of the photograph, there are two phialides, both with a collection of conidia at their apices, where they remain after being produced.
(LPCB, DMD-108, 1000X)
Acremoniumspecies - another view of the tapering phialides extending from their parent hyphae where elongated, ellipsoidal conidia lay gathered.
(LPCB, DMD-108, 1000X)
Acremoniumspecies - pretty much the same as in the above photo. The phialide at the very top of the photo appears to have produced only one conidium. Perhaps it is younger than the others.
(LPCB, DMD-108, 1000X)
Acremoniumspecies - another photo of tapering phialides and the ellipsoidal conidia gathered around the apices. (LPCB, DMD-108, 1000X)
Acremoniumspecies - insert -one tapering phialide with individual conidia gathered at the apex.
(LPCB, DMD-108, 1000X)
Acremoniumspecies - Two phialides, side by side producing large quantities of conidia.
(LPCB, DMD-108, 1000+10X)
Acremoniumspecies - tapering phialide with single ellipsoidal conidia at the apex. A slight collarette can be seen remaining around the apex. Conida already produced almost seem to have fallen down and accumulated around the base of the phialide and hypha.
(LPCB, DMD-108, 1000+10X)
Acremoniumspecies - as previously -another view of the tapering phialides and the balls of conidia adhering to the apex of the phialides where they were produced.
(LPCB, DMD-108, 1000+10X)
Acremoniumspecies - As previously.
(LPCB, DMD-108, 1000X)
Acremoniumspecies - a few barren phialides can be seen and the large mass of dispersed, primarily single celled conidia seen throughout.
(LPCB, DMD-108, 1000X)
Acremoniumspecies may be confused with Verticilliumand some isolates of Fusarium where macroconidia are not present. Rate of growth and colony morphology differs from that of Acremonium species and may provide initial clues for differentiation.
[i]Mycetoma, or maduromycosis, is a slow-growingbacterial or fungalinfectionfocusedin onearea of thebody,usuallythefoot. Approximatelyonemonth or moreaftertheinjury,a painless noduleformsundertheskinsurface. The nodules develop into a tumor which produces sinuses to drain fluid. Thefluidcontainstinygrains, which may be a clue as to the type of organism is causing the infection.
* * *